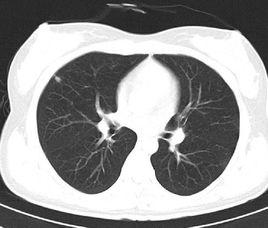
胸部CT 胸部CT

意義
臨床意義
1.胸壁:可以發現胸片上不能顯示的石棉肺伴胸膜增厚;胸腔積液時,若發現胸膜小結節或腫塊,有助於轉移瘤和間皮瘤的診斷;根據胸膜腫塊的CT值可鑑別包裹性積液、局限性間皮瘤及胸膜外脂肪瘤;藉助CT增強可以診斷胸壁血管瘤;能很好地顯示肋骨骨折及肋骨的破壞。
2.肺臟:對周圍型肺癌的早期診斷有價值;發現主支氣管、肺葉支氣管及肺段支氣管狹窄或截斷時,對診斷中央型肺癌有幫助;高解析度CT(HRCT)可能顯示胸片不能顯示的瀰漫性間質性病變,有助於早期診斷和鑑別診斷;還可發現胸片上不能顯示的肺大泡、支氣管擴張、較小的肺結核空洞等。
3.縱隔:可以發現胸片上不能發現的增大的淋巴結,根據腫塊的CT值和部位,有助於縱隔腫塊的定性診斷;還可用於鑑別脂肪性、囊性、實性腫塊,增強掃描可診斷出肺動脈瘤及主動脈瘤。
4.CT血管造影可用於肺動脈血管造影檢查,對亞段以上肺動脈血管分支均有較好的顯示,可用於肺栓塞的診斷。
5.CT仿真內鏡可無損傷性顯示段支氣管及亞段支氣管,能從支氣管腔鼻塞和狹窄的遠端觀察病變;同時顯示多方位的管腔外的解剖結構,且對壁外腫瘤能精確定位、確定其範圍。
6.CT由於是斷層掃描,並且具有比胸片高10倍的密度解析度,能夠輕易發現直徑小於2mm的微小結節。
掃描意義
1.有助於對X線胸片發現的問題作出定性診斷:腫塊:(1)鑑別腫塊為囊性、實質性、脂肪性或鈣化性;(2)明確腫塊的位置、範圍,查明腫塊與縱隔的解剖聯屬。
2.根據臨床需要可檢出X線胸片未發現的隱性病源:(1)查明有無微小轉移瘤,可顯示腫瘤的存在及其部位、大小、數目,以便制訂治療方案。(2)CT引導經皮穿刺活檢,使某些腫塊能得到組織學診斷。(3)對X線胸片及纖維支氣管鏡檢查陰性,而痰瘤細胞陽性,應作CT以查明肺內瘤源。
3.CT對支氣管浸潤、狹窄的程度及形態遜於X線斷層攝片,更次於支氣管造影。